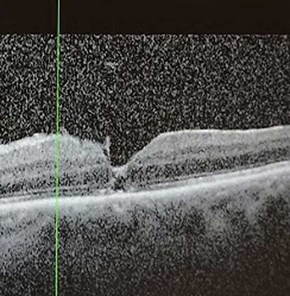

The evolution of ophthalmic surgical practice over the past seven decades has been extraordinary. Within this period, the first vitrectomy was performed, establishing a foundation for what is now an operation performed thousands of times per year in the UK [1,2]. However, whilst clinicians have come to see vitrectomy surgery as ‘routine’, for patients it represents a significant life event.
A compelling illustration of this can be found in the testimony of a patient – a professional photographer and fine artist – who shared their experience of suffering with a macula hole and undergoing macula hole surgery [3]. Their response to the experience has provided a unique descriptive and visual representation of what patients experience with macula holes and what their recovery may look like following surgery. At each stage of their pre- and postoperative journey, the patient has digitally edited photographs to demonstrate what they were able to see, offering a unique insight to the patient experience.
The patient wished to publicly share her experiences with fellow patients and clinicians to bridge the gap between clinical practice and patient perceptions, and offer reassurance to others facing similar interventions.
The patient’s journey
The patient was referred to the vitreo-retinal clinic by her local optician, with a history of sudden onset blurred vision, distortion and an awareness of a dark grey patch in their left eye. As an active photographer, they were aware of the potential impact this may have on their work. The patient illustrated what they were able to see from this eye in Figures 1 and 2.
Assessment in the surgical retina clinic revealed a macular hole with cataract and Figure 3 shows their preoperative macula optical coherence tomography (OCT) scan. The patient was promptly placed on the surgical waiting list and underwent vitrectomy with internal limiting membrane peel, C2F6 gas tamponade, phacoemulsification with intraocular lens insertion and retinopexy.

Figure 1: Vision from left eye preoperatively [3].

Figure 2: Distortion noted in left eye preoperatively [3].

Figure 3: OCT scan of macular hole preoperatively [3].
Week 1 (postoperatively)
At one week postoperatively, the patient described that approximately three-quarters of her visual field was occupied by the gas bubble. They described their vision as magnified and noted floaters in the superior aspect of their vision like “gnats everywhere I go” [3]. Figures 4 and 5 are an illustration of what the patient was experiencing at this stage of their recovery.

Figure 4: Week 1 postoperatively looking at hand [3].

Figure 5: Week 1 postoperatively looking at sky with floaters
– ‘starlings in their thousands’ [3].
Week 2
During the second postoperative week, the gas bubble had diminished to just over half of the patient’s visual field. The patient reported that routine activities requiring binocular vision, such as reading and watching television, became increasingly disorientating and difficult to manage. Their vision whilst reading and looking down has been illustrated in Figures 6 and 7. At their follow-up review, the OCT confirmed anatomical resolution of the macular hole, as demonstrated in Figure 8.
Despite this positive clinical finding, the patient understandably found the uncertainty around whether their visual function would continue to improve or plateau, difficult, particularly given they were an established photographer. It highlights the importance of maintaining a holistic approach and supporting patients postoperatively even when anatomical success is achieved.

Figure 6: Week 2 postoperatively reading a book [3].

Figure 7: Week 2 postoperatively looking at feet [3].
Figure 8: Macula OCT 2 weeks postoperatively [3].
Week 3
At this stage, the patient noticed the gas bubble continuing to reduce in size, occupying less than half of their visual field. The patient reported the appearance of a new, distinct mobile bubble that had separated from the primary bubble. Over subsequent days, additional smaller bubbles branched off before gradually diminishing in size. Although these satellite bubbles eventually resolved, they remained a prominent feature of the patient’s subjective experience, offering insight into the dynamic nature of intraocular gas resolution. Figures 9 and 10 shows what the patient was visualising during this period.

Figure 9: Week 3 postoperatively looking at lap [3].

Figure 10: Week 3 postoperatively as bubble breaks up [3].
Week 4
At day 29 postoperatively, the patient described that the intraocular gas bubble had reduced substantially (Figure 11), with a corresponding decrease in floaters. However, the patient reported ongoing flashes and discomfort. At their scheduled review, clinical examination confirmed satisfactory progress with no complications detected.

Figure 11: Week 4 postoperatively looking at feet [3].
Week 8
At eight weeks, OCT confirmed successful closure of the macular hole as shown in Figure 12. Despite this, the patient continued to experience central metamorphopsia that interfered with reading, a commonly reported persisting symptom despite macula hole surgery [4].
Nevertheless, they reflected positively on their adaptation, stating that “each day [their] brain feels more at ease and less stressed by the differences between [their] eyes” [3]. This highlights not only the physiological recovery but also the process of neuroadaptation following surgery.

Figure 12: Macula OCT scan 8 weeks postoperatively [3].
Discussion
This fascinating insight from a patient demonstrates the complex interplay between anatomical success, functional recovery and the patient experience of macular hole surgery both pre- and postoperatively. Whilst OCT confirmed closure of the macular hole, subjective symptoms, including distortion, metamorphopsia, flashes and discomfort, continued to shape the patient’s perception [5].
This visual representation of the patient’s perioperative period helps clinicians better appreciate what patients experience and understand the visual challenges beyond the level of visual acuity measured in clinic. It is also helpful for clinicians to have an insight into the patient’s experience when counselling patients through their operative journey. This resource can be useful to share with future patients so that they can better understand what to expect after macular hole surgery.
References
1. Machemer R, Buettner H, Norton EWD, Parel JM. Vitrectomy: a pars plana approach. Trans Am Acad Ophthalmol Otolaryngol 1971;75(4):813–20.
2. Madi HA, Keller J. Increasing frequency of hospital admissions for retinal detachment and vitreo-retinal surgery in England 2000–2018. Eye (Lond) 2022;36(8):1610–4.
3. Stolow N. THROUGH THE BUBBLE: The story of my Macular Hole: Vitrectomy and Cataract Surgery. Naomi Stolow Photography 2025:
https://www.naomistolow.com/single-post/
my-macular-hole-vitrectomy-surgery
[Link last accessed January 2026]
4. Fukuyama H, Ishikawa H, Komuku Y, et al. Comparative analysis of metamorphopsia and aniseikonia after vitrectomy for epiretinal membrane, macular hole, or rhegmatogenous retinal detachment. PLoS ONE 2020;15(5):e0232758.
5. Woudstra-de Jong JE, Busschbach JJ, Manning-Charalampidou SS, et al. Assessment of patient-reported outcomes in vitreomacular interface disorders: A systematic literature review. Surv Ophthalmol 2025;70(4):685–94.
Declaration of competing interests: None declared.
Acknowledgement
We would like to thank our patient, Naomi Stolow (BAHons) who is a photographer and fine artist. She commented: “Looking online, I found nothing relevant from the patient's viewpoint to relieve my fears so felt compelled to record the visual experiences myself. I received numerous messages of gratitude from fellow patients who have had vitrectomy surgery and have found the resource reassuring as they are seeing the same things and are relieved to finally be able to explain to others what they are experiencing. It has also greatly helped people preparing for surgery as it has given them an understanding of what to expect as they recover”. The patient's full story of her macula hole recovery can be seen on her website: www.naomistolow.com/blog


